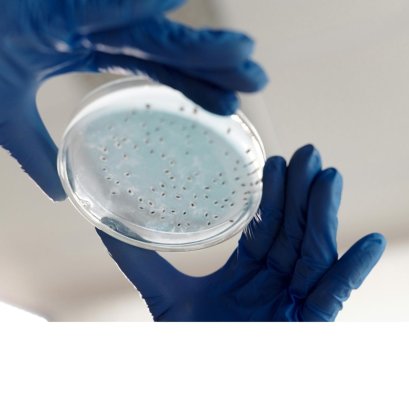
Ep.21 การทดสอบทางชีวภาพ

blog
Longevity เทรนด์ใหม่ที่กำลังเปลี่ยนโลกสุขภาพและความงาม
Texture (เนื้อสัมผัส) ของผลิตภัณฑ์ไม่ใช่แค่ความรู้สึกขณะทา
การทดสอบคุณภาพทางประสาทสัมผัสของเครื่องสำอางใช้ประสาทสัมผัส 5 อย่าง ได้แก่ การมองเห็น การได้กลิ่น การลิ้มรส การได้ยิน และการสัมผัส
อุณหภูมิเป็นปัจจัยสำคัญในการเร่งการสลายตัวของสารในสูตรผลิตภัณฑ์ และระหว่างการทดสอบจะมีเกณฑ์การประเมินผลโดยการตรวจสอบคุณสมบัติทางกายภาพ
ความสามารถของผลิตภัณฑ์ในการคงสภาพองค์ประกอบทางเคมีทั้งหมด เช่น สารออกฤทธิ์ สารกันเสีย และสารช่วยต่าง ๆ
ผลิตภัณฑ์ดูแลจุดซ่อนเร้นช่วยรักษาสุขอนามัย ทั้งในช่วงเวลาปกติและช่วงมีประจำเดือน
ผลิตภัณฑ์เครื่องสำอางสำหรับเด็กจะอ่อนโยน ปลอดภัยต่อผิวบอบบาง ใช้ส่วนผสมจากธรรมชาติเพื่อลดการแพ้ระคายเคือง และมีกลิ่น สี ที่เหมาะกับเด็ก
เส้นผม คือ เส้นใยเคราตินบางๆที่มีความยืดหยุ่นสูง พบได้ตามผิวหนัง ยกเว้น ฝ่ามือ ฝ่าเท้า และริมฝีปาก
ปัจจุบันลิปสติกมากหลากหลายเฉดสี และเนื้อลิปมีเยอะแยะมากมายให้เลือก
ปัจจุบันลิปสติกมากหลากหลายเฉดสี และเนื้อลิปมีเยอะแยะมากมายให้เลือก
รังสีอัลตราไวโอเลตหรือรังสียูวี (Ultraviolet:UV) รังสียูวีมีพลังงานมากที่สุด และด้วยพลังงานที่มากก็ยิ่งมีอันตรายมากเช่นกัน
Moisture หมายถึงความชุ่มชื้นที่มาจากน้ำหรือของเหลวอื่นๆ แต่ Moisturizer หมายถึงส่วนผสมที่เพิ่มความชุ่มชื้นให้กับผิว
ผิวเสื่อมสภาพหรือผิวชรานั้นจะมีความยืดหยุ่นน้อยลง หยาบกร้าน สีผิวไม่สม่ำเสมอ และมีริ้วรอย
สิวเกิดจากการอักเสบของรูขุมขนและต่อมไขมันถูกจัดเป็นโรคทางผิวหนังที่พบมากที่สุด มักจะเริ่มเกิดสิวได้ตั้งแต่อายุ 12 ปี
โดยทั่วไปก็จะแบ่งออกตามสภาพผิว เช่น ผิวแห้ง ผิวมัน ผิวปกติ แตยังมีการแบ่งประเภทผิวแบบอื่นๆอยู่อีกด้วย ไม่ว่าจะเป็น Phototype หรือตามเพศ
รูปแบบของเครื่องสำอาง จะจำแนกตามลักษณะทางกายภาพ เช่น ของเหลว กึ่งของเหลว ของแข็ง
อ้างอิงจากพระราชบัญญัติเครื่องสำอาง พ.ศ. 2558 ให้ความหมายเครื่องสำอางไว้ว่า "เครื่องสําอาง"